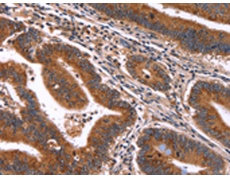
一抗

中文名稱: 兔抗HACE1多克隆抗體
英文名稱: Anti-HACE1 rabbit polyclonal antibody
相關(guān)類別: 一抗
儲(chǔ) 存: 冷凍(-20℃)
宿 主: Rabbit
抗 原: HACE1
反應(yīng)種屬: Human, Mouse, Rat
標(biāo) 記 物: Unconjugate
克隆類型: rabbit polyclonal
技術(shù)規(guī)格
|
Background: |
HACE1 (HECT domain and ankyrin repeat containing, E3 ubiquitin protein ligase 1), also known as KIAA1320, is a 909 amino acid protein that localizes to both the cytoplasm and the endoplasmic reticulum and contains one HECT domain and six ANK repeats. Expressed in kidney, heart and brain, HACE1 functions as an E3 ubiquitin-protein ligase that interacts with the proteasome and is thought to play a role in protein degradation. HACE1 is downregulated in Wilms tumor, suggesting a possible role in tumor suppression. |
|
Applications: |
ELISA, IHC |
|
Name of antibody: |
HACE1 |
|
Immunogen: |
Synthetic peptide of human HACE1 |
|
Full name: |
HECT domain and ankyrin repeat containing E3 ubiquitin protein ligase 1 |
|
SwissProt: |
Q8IYU2 |
|
ELISA Recommended dilution: |
2000-5000 |
|
IHC positive control: |
Human colon cancer and Human ovarian cancer |
|
IHC Recommend dilution: |
100-200 |

 購物車
購物車 幫助
幫助
 021-54845833/15800441009
021-54845833/15800441009